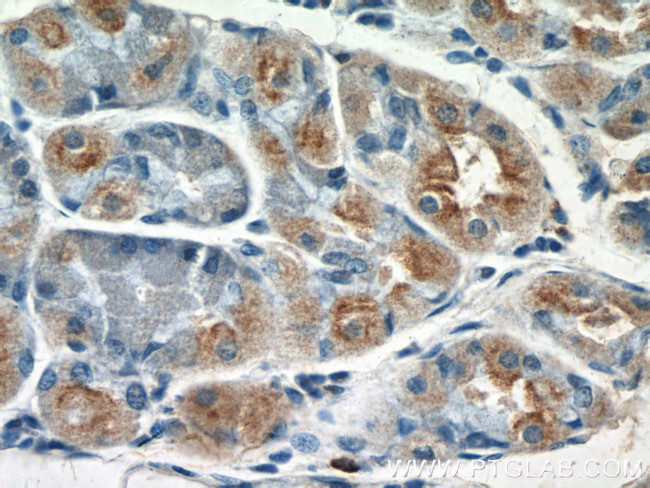
GDAP2 Antibody in Immunohistochemistry (Paraffin) (IHC (P))

Search
Proteintech
GDAP2 Polyclonal Antibody
{{$productOrderCtrl.translations['antibody.pdp.commerceCard.promotion.promotions']}}
{{$productOrderCtrl.translations['antibody.pdp.commerceCard.promotion.viewpromo']}}
{{$productOrderCtrl.translations['antibody.pdp.commerceCard.promotion.promocode']}}: {{promo.promoCode}} {{promo.promoTitle}} {{promo.promoDescription}}. {{$productOrderCtrl.translations['antibody.pdp.commerceCard.promotion.learnmore']}}
产品信息
17246-1-AP
种属反应
宿主/亚型
分类
类型
抗原
偶联物
形式
浓度
规格
纯化类型
保存液
内含物
保存条件
运输条件
产品详细信息
Immunogen sequence: CYRNVLQLA KEQSMSSVGF CVINSAKRGY PLEDATHIAL RTVRRFLEIH GETIEKVVFA VSDLEEGTYQ KLLPLYFPRS LKEENRSLPY LPADIGNAEG EPVVPERQIR ISEKPGAPED NQEEEDEGLG VDLSFIGSHA FARMEGDIDK QRKLILQGQL SEAALQKQHQ RNYNRWLCQA RSEDLSDIAS LKALYQTGVD NCGRTVMVVV GRNIPVTLID MDKALLYFIH VMDHIAVKEY VLVYFHTLTS EYNHLDSDFL KKLYDVVDVK YKRNLKAVYF VHPTFRSKVS TWFFTTFSVS GLKDKIHHVD SLHQLFSAIS PEQIDFPPFV LEYDARVRST RSSPSPGMVY (148-496 aa encoded by BC013132)
靶标信息
GDAP2 is a protein coding gene and gene ontology (GO) annotation includes lysosomal membrane; response to retinoic acid.
仅用于科研。不用于诊断过程。未经明确授权不得转售。
篇参考文献 (0)
生物信息学
蛋白别名: dJ776P7.1; Ganglioside-induced differentiation-associated protein 2; Ganglioside-induced differentiation-associated-protein 2; unnamed protein product
基因别名: C77050; D3Ertd801e; GDAP2; MACROD3; SCAR27
UniProt ID: (Human) Q9NXN4, (Mouse) Q9DBL2, (Rat) Q66H63
Entrez Gene ID: (Human) 54834, (Mouse) 14547, (Rat) 362004